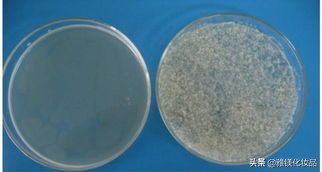
zpt洗发水危害,zpt去屑洗发水

市面上打着去屑功能的洗发水已经是屡见不鲜了,有传言说孕妇使用了ZPT去屑洗发水可能会导致胎儿畸形,什么是ZPT洗发水呢?
即使是国际大牌也都少不了它,比如,海飞丝、吕、清扬、沙宣、飘柔、欧莱雅、多芬、潘婷、丝蕴、施华蔻等都有添加。

ZPT是我国允许使用的防腐剂、去屑剂,能够治疗头屑和脂溢性皮炎。去屑洗护产品中ZPT含量的上限浓度为1.5%,这个标准是参考了日本、欧盟、美国等国家和地区的相关规定,既保证了去屑效果也保证了安全性。
作用机理
1、降低降低细胞内ATP水平;
2、影响细菌蛋白质合成;
3、直接或者间接影响细胞内质子泵运输;
4、并作用于细菌细胞膜磷脂以破坏细胞膜结构等多种途径抑制细菌生长。
多种机制协同作用也使得微生物对于ZPT耐药性产生的可能性降低。因此,ZPT的抗菌抑制头屑生长作用显著。

ZPT的毒性研究
有研究表明,ZPT在浓度大于0.01 g/ L时对海胆卵细胞和胚胎具有毒性,含有ZPT的洗发水能诱发鱼类幼虫的背骨出现波浪状畸形。
但是对哺乳动物来说,用大鼠和兔子口服及外用给药都没有见到ZPT有毒性,同样在ZPT使用的60年中,也没有人类胚胎毒性的报道出现。
在基因毒性上,确实有研究表明ZPT能够诱发基因损伤,引起氧化应激反应、导致细胞凋亡。

ZPT是不是就不能用了?
上面ZPT可以引起细胞及基因毒性,那我们用ZPT的洗发水不是危险很高?
其实并不会。因为压根就没有机会让ZPT接触到人体活性细胞。
外用大部分只能驻留在角质层外层,部分可沉积在表皮层,或溶于毛囊中皮脂而存留在毛囊中,几乎不发生透皮吸收。
科学研究用同位素标记法发现,附着在头发和角质层的ZPT很难被水清洗掉,同时也难以被人体透皮吸收,只能随皮肤角质层自身代谢而减少,因此可以持久和安全地发挥抗菌作用。
小总结
ZPT是法规允许成分,并且是市售产品中用的最多的一种去屑剂。
ZPT确实对活细胞有一定毒性,但是ZPT外用,只会存在皮肤角质层和毛囊皮脂中,不会更深入。
所以用含有ZPT的去屑产品,大家可以放一万个心!